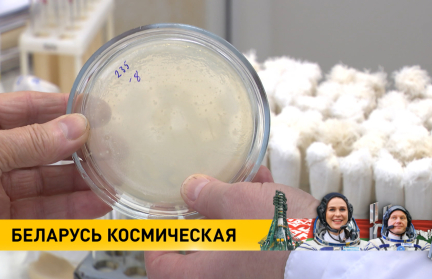

Марина Василевская прилетела в Минск

Первые минуты на родной земле! Марина Василевская, первая белорусская женщина-космонавт вернулась домой. Из Звездного городка в Минск она добиралась куда быстрее, чем с орбиты на Землю.
Самолет с белоруской на борту приземлился в столице рано утром. Прилета белорусского космонавта с нетерпением ждали сотни людей.
В аэропорту Марину Василевскую встречали цветами и хлебом-солью. И первые тех, кто собрался в аэропорту – слова благодарности и искренней гордости. И, конечно же, лучезарная улыбка Василевской, ставшая уже фирменной, сорвала овации.
Первая белорусская женщина-космонавт Марина Василевская призналась, что истосковалась по Родине. И этот полет в космос она посвятила Беларуси и нашему народу.
«Я очень рада ступить на нашу белорусскую землю», – Марина Василевская.
Море эмоций и, кажется, вопросы не закончатся никогда. Марину Василевскую журналисты долго не хотели отпускать. Она – и это не фигура речи – нарасхват. По возвращении в Беларусь сразу из аэропорта Марина отправилась на встречу с Президентом.
Фото: БЕЛТА
Еще по теме
Ученые подводят итоги экспериментов, которые Марина Василевская проводила на МКС. Подробнее – в репортаже ОНТ
«Будет дополнено»: белоруска Марина Василевская успешно вернулась с экспедиции на МКС – что дальше?

В Беларуси подводят итоги программы исследований космонавта Марины Василевской











